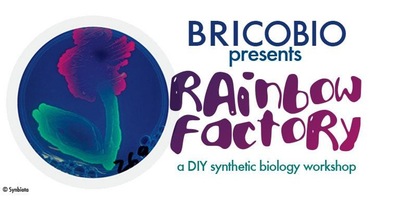
Rainbow Factory - DIY Synthetic Biology

Design and build your own custom DNA constructs and then transform them into bacteria! In just a few hours, you can create a custom plasmid capable of producing fluorescent proteins in E. coli. This workshop is based on a genetic engineering system provided by Synbiota. Throughout the workshop, you’ll be doing mostly hands-on work in assembling your constructs. There’ll be a few breaks from the hands-on work where we’ll you’ll learn about making in biology. Each person will get to go home with their own genetically engineered organism!
Popularité
Distance
Prix
Rainbow Factory - DIY Synthetic Biology
1
Toutes les sorties
30
Concerts
38
Art & Musées
17
Festivals & Marchés
104
Party & Nightlife
3
5 à 7 & Réseautage
7
Théâtre & Humour
90
Jeux & Attractions
264
Déjeuners & Brunch
1720
Restaurants étonnants
15
LGBT
944
Sports & Fitness
111
Danse
1015
Poutines
41
Coups de cœur de So Montréal
Rainbow Factory - DIY Synthetic Biology
variable
29 novembre 2015 à 10h00 au 29 novembre 2015 à 17h00
Description
PLUS D'INFOS